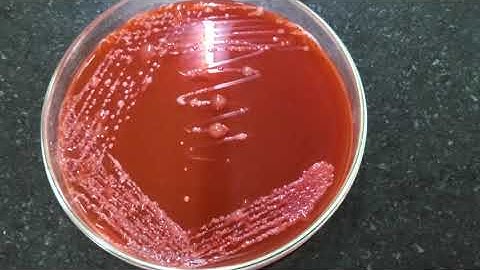
Isolation of Rhizobium on CRYEMA from Root nodules

⬇ DOWNLOAD NOW
Kalau muncul iklan pop-up, tutup lalu klik tombol kembali
Download lagu Isolation of Rhizobium from Root nodule #Isolation secara gratis hanya untuk keperluan promosi. Dukung artis favorit kamu dengan membeli musik original di iTunes atau platform resmi lainnya.
 Isolating rhizobia from root nodules
Isolating rhizobia from root nodules
 Medicago and Rhizobium - Root Nodule formation in Barrel Clover
Medicago and Rhizobium - Root Nodule formation in Barrel Clover
 RHIZOBIUM ISOLATION VIDEO
RHIZOBIUM ISOLATION VIDEO
Isolation of Rhizobium on CRYEMA from Root nodules
Isolation of Rhizobium on CRYEMA from Root nodules
 Root Nodule Formation | Biological Nitrogen Fixation | Rhizobium | Mineral Nutrition | NEET Biology
Root Nodule Formation | Biological Nitrogen Fixation | Rhizobium | Mineral Nutrition | NEET Biology
 VAC patho isolation Rhizobium
VAC patho isolation Rhizobium
 Isolation of Rhizobium from Root nodules
Isolation of Rhizobium from Root nodules
 Experiment:-Isolation of rhizobium from root nodule.
Experiment:-Isolation of rhizobium from root nodule.